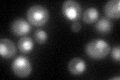
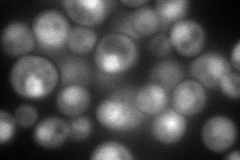
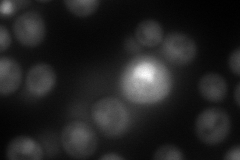
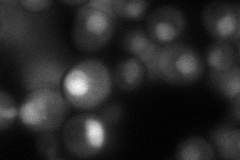
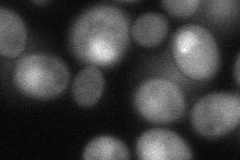

View description
Transportin or cytosolic karyopherin beta 2; functions in the rg-nuclear localization signal-mediated nuclear import/reimport of mRNA-binding proteins Nab2p and Hrp1p; regulates asymmetric protein synthesis in daughter cells during mitosis
Localization:
Intensity:
Fold change:
Significance:
-
C’ GFP library in SD
nucleus53.7 -
N' NOP1pr-GFP in SD
cytosol,nucleus106.581 -
N' TEF2pr-mCherry in SD
nucleus151.129 -
N' NATIVEpr-GFP in SD
nucleus71.4266 -
N' TEF2pr-VC and Cyto-VN in SD
nucleus61.7563 -
C’ GFP library in SD+DTT

nucleus41.70.77No -
C’ GFP library in SD+H2O2

nucleus50.570.94No -
C’ GFP library in Starvation Media

nucleus37.520.69No -
C’ GFP library on the background of Pup2-DaMP

nucleus -
C’ GFP library on the background of CCT mutant

nucleus58.50661.08924No
